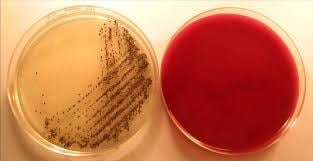
image 1

Clostridioides difficile formerly known as Clostridium difficile is a bacterium which is most commonly found in soil and in hospital environments which is responsible for causing diarrheal illness.

It produces a toxin that infects people who have been taking antibiotics and is responsible for damaging intestinal mucosa, leading to conditions from mild infections to life-threatening infections such as colitis.
Taxonomy and Classification
Domain: Bacteria
Kingdom: Bacillati
Phylum: Bacillota
Class: Clostridia
Order: Peptostreptococcales
Family: Peptostreptococcaceae
Genus: Clostridioides
Species: C. difficile
Morphology and Microscopy
- Gram-positive rod-shaped bacilli
- Approximately 0.6 µm wide and 3-7 µm long in size that occur singly or in chain.Â
- Spore-forming
- Motile
- Capsulated
Under microscope they appear as pink colored rod shaped bacilli.
Cultural and Growth Characteristics
- Obligate anaerobes but can grow under micro-aerophilic conditions.
- Optimum temperature: 37ËšC
- Optimum pH: 7.2
- On Nutrient Agar: large, flat, filamentous and translucent colonies with irregular edges.
- On Blood Agar: Shows double zone of β-hemolysis.
- On MacConkey Agar: Forms green fluorescent colonies.
- On Marshal’s Medium: produce black colonies
- On Robertson’s Cooked Meat Broth: Proteolytic species turn meat black with a foul smell while saccharolytic species turn meat pink. Production of gas.
- On Litmus Milk: acid clot and stormy fermentation.
Figure 1: Cultural growth of C. difficile
Source: https://www.researchgate.net/figure/Culture-of-C-difficile-from-a-stool-sample-after-24-h-of-incubation-on-IDCd-medium_fig1_45951767
Biochemical and Identification Tests
| Tests | Results |
| Gram Staining | Negative |
| Catalase | Negative |
| Oxidase | Negative |
| Indole | Negative |
| OF (Oxidative-Fermentative) | Anaerobic |
| VP (Voges Proskauer) | Negative |
| H2S | Positive |
| Urease | Negative |
| Gelatin Hydrolysis | Positive |
| Nitrate Reduction | Negative |
| Fermentation of | |
| Glucose | Positive |
| Maltose | Negative |
| Ribose | Negative |
| Lactose | Negative |
| Mannitol | Positive |
| Fructose | Positive |
| Arabinose | Negative |
| Cellobiose | Positive |
| Xylose | Negative |
| Sucrose | Negative |
| Mannose | Positive |
| Galactose | Negative |
| Starch | Negative |
| Glycerol | Negative |
| Trehalose | Negative |
| Glycogen | Negative |
| Enzymatic Reactions | |
| Esculin Hydrolysis | Positive |
| Lecithinase | Negative |
| Casein Hydrolysis | Negative |
| Lipase | Negative |
| Tryptophan Deaminase | Negative |
Pathogenesis and Virulence Factors
- The normal flora of the intestine is disturbed by broad-spectrum antibiotics.
- C. difficile then enters into the gut after the loss of protective bacteria.
- After that, the infection starts by the consumption of spores of C. difficile.
- These spores then resist the gastric acid and move to the intestine.
- After arriving in the colon, the spores sprout into vegetative cells which are aided by bile salts.
- After that the bacteria stick to the mucosal surface of the intestine which then multiply quickly.
- Toxin A known as entertoxin and Toxin B known as cytotoxin are produced which obstruct the cytoskeleton of epithelial cells.
- This results in injury of mucosa causing increased permeability of intestine, apoptosis of epithelial cell and necrosis.
There are various virulence factors which contribute in pathogenicity of C. difficile which are explained below:
- Toxin A (Enterotoxin)
- Is 308 kDa in size which is proteinaceous in nature encoded by tcdA.
- It disturbs compact linkage among epithelial cells.
- It is responsible for the secretion of fluid which causes diarrhea.
- Causes inflammation marked by the presence of neutrophil.
- Toxin B (Cytotoxin)
- Is 269 kDa in size and encoded by tcdB.
- Is more potent than toxin A.
- Causes disruption of cytoskeletal by inactivating Rho GTPase.
- Is responsible for causing rounding of cells, apoptosis and mucosal damage.
- Cytolethal Distending Toxin (CDT)/Binary Toxin
- Found in hypervirulent strains such as ribotype 027 and 078.
- Helps in attachment of bacteria to epithelial cells of the intestine.
- Causes changes in the cytoskeleton.
- Surface Layer Proteins (SLPs)
- Responsible for the increased attachment to the mucosal surface of the gut.
- Helps in evasion of the immune system.
- Cell Wall Protein 84
- Assist in the release and distribution of bacteria in the host.
- Helps in attachment and colonization of bacteria to the epithelial cell of gut.
- Biofilm Formation
- Protects bacteria from host immune response and antibiotics.
- It contributes to infection reoccurrence and duration of infection.
- Flagella
- Helps in motility and aid in bacterial colonization and formation of biofilm.
- Spore Formation
- Helps to protect against environmental stresses such as heat, desiccation etc.
- Assists in transmission and presence of bacteria in hospital environments.
Epidemiology and Transmission
C. difficile is an important causative agent associated with hospital-based post-antibiotic colitis which occupies up to 3-5% of the intestines of healthy people without manifesting any symptoms. Early 2000s data shows remarkable rise in the incidence of infections by C. difficile. Between 2003 to 2006, infection by C. difficile was found to be more severe and frequent with more likely to relapse compared to those described previously which was found predominantly in North America and Europe and assigned to the emergence of the strain known as BI, NAP1 or ribotype 027. These strains are more virulent compared to others which is due to the increased production of toxin compared to that of previous strains. In year 2005, in Netherland there was emergence of infection caused by C. difficile ribotype 078 which showed severity same as those caused by ribotype 027. Similarly, in 2007, infection by C. difficile was a leading cause of gastroenteritis related with 5 fold rise in death. Likewise, an article published in 2011 by Centers for Disease Control and Prevention showed an increase in incidence of infection by C. difficile across ten geographic areas of the United States compared to that of previous decade with higher infection rate in females and old aged people. Half a million people from America are annually infected by C. difficile.
The common reservoir of C. difficile is human however it is also present in various animals. C. difficile is transmitted mainly via fecal-oral route. Transmission of spores of this organism is common in places such as hospitals and long-term care facilities, where often people touch or share common objects. It is commonly transmitted through following methods:
- Contaminated Surfaces: Objects like door handles, bed sheets, bathroom fixtures etc. contaminated with stool can spread the bacteria.
- Unwashed Hands: If people do not wash hands after the use of bathroom or before having food C. difficile can spread.
- Shared Items: Shared items like medical equipment especially in healthcare settings can cause the spread of C. difficile.
Clinical Manifestations
Symptoms generally start within 5-10 days after medications which can begin as soon as the first day or up to 3 months later. It causes various types infection explained as below:
- Asymptomatic Colonization
- Carriers carry bacteria without manifesting any symptoms
- Mild to Moderate Infection
- Watery DiarrheaÂ
- Cramp and tenderness in abdomen
- Low grade fever
- Severe Infection
- Watery Diarrhea for more than 10 times a day
- Severe pain and cramp in belly
- Increase in heart rate
- Dehydration
- Nausea
- Fever
- Increase in WBC count
- Loss in appetite
- Loss in body mass
- Swelling in belly
- Nausea
- Presence of pus or blood in stool
- Complications
- Toxic megacolon: massive dilation in colon, possibility of perforation.
- Sepsis: systemic infection caused by the distribution of toxins or bacteria.
- Pseudomembranous colitis: formation of yellowish plaques on mucosa of colon.
- Dehydration and Electrolyte Imbalance: Caused due to severe diarrhea.
- Reactive arthritis: causes reactive arthritis, leading to inflammation, pain and swelling in joints and other parts of the body.
- Fluid Leakage: fluids leak into the abdominal cavity causing protein loss from colon resulting in low albumin level.
- Recurrent Infection: Found in 20-30% of patients.
- Rare Manifestations
- Perforation in Bowel
- If untreated, multi-organ failure
Risk Factors
Following are the risk factors for the infection with C. difficile:
- People under medications with antibiotics such as Cephalosporins, Penicillins, Clindamycin and Fluoroquinolones are at risk.
- People staying in health care settings or have been in healthcare settings are at higher risk as this bacteria spreads through hands, bedside tables, telephone, toilets and sinks.
- Those having a serious illness or medical procedure can increase the risk of infection with C. difficile such as chronic kidney disease, inflammatory bowel disease, person on chemotherapy, digestive tract procedures and surgery of stomach.
- Old people above 65 age are at higher risk with infection by C. difficile.
Laboratory Diagnosis
- Sample Collection and Transportation
- Fresh feces are collected as the sample.
- Specimens which are collected for the detection of toxins should be kept at 4ËšC.
- Culture
- Cycloserine Cefoxitine Fructose Agar (CCFA), Commercially available Chromogenic Media and Clostridium difficile Selective Agar are used for the culture.
- Patients’ fresh diarrheal stool is used for the culture.
- Culture cannot alone be used for the diagnosis of infection by Clostridium difficile, as it cannot identify toxin producing strains.
- Examination of Colon
- The inside part of the colon is checked either by colonoscopy or flexible sigmoidoscopy.
- A flexible tube with a small camera at one end is inserted into the colon to observe the infected areas.
- Enzyme Immuno Assay for detection of toxin
- Used for the detection of toxin A and toxin B in fecal samples.
- Is most commonly used as it is low in cost and provides results within hours.
- However it is less sensitive having values less than 50-90%.
- Glutamate Dehydrogenase (GDH) detection using Immunoassay
- Detection of GDH, an antigen of C. difficile, is used as a surrogate marker for the presence of C. difficile strains.
- It is used as a screening test.
- Have high sensitivity but low specificity.
- Molecular tests
- Nucleic Acid Amplification Test (NAATs) is used to detect RNA or DNA sequences.Â
- Uses either PCR or Loop-mediated isothermal amplification to target CD toxin genes.
- Have high sensitivity and specificity.
- Imaging Tests
- X-ray or CT scan is used to observe following:
- Enlarged bowel
- Perforation in the lining of colon
- Thickened wall of colon
- Testing with biomarkers
- Inflammation caused by C. difficile toxin can be tested in feces using Cytokines, Myeloperoxidase, Lactoferrin and Calprotectin.
- Calprotectin and Lactoferrin are found in both intestinal inflammatory processes and inflammatory bowel disease.
- These biomarkers are not specific but have the possibility to be used as the indicators of severity of disease.
Treatments
- Antibiotics
- VancomycinÂ
- Fidaxomicin
- Metronidazole
- Surgery
Surgery is required if there is:
- Severe pain
- Organ failure
- Toxic megacolon
- Inflammation around the stomach area
For recurrent infection there are options which are explained as:
- Repeat antibiotic therapy
- Use of different antibiotics.
- Longer prescription of the same antibiotics.
- Fecal Microbiota Transplant
- If treatment by antibiotic fails to cure disease, fecal transplant is used for the treatment.
- In this transplant, feces from a healthy donor is transmitted to the colon of diseased person.
- Antibody-based therapy
- Bezlotoxumab is a human antibody against C. difficile toxin B.Â
- It is used to reduce the risk of repeated infection by C. difficile.
- Probiotics
- Are food or supplements which contain microorganisms to increase good bacteria in the body.
- Â However, the exact role of these probiotics are still unknown.
Prevention and Control
Numbers of control measures are implemented to prevent the transmission of the bacteria which are explained below:
- Isolation
- There should be contact precautions for both the suspected and confirmed cases until the diarrhea is resolved or it is determined as non infectious.
- Hand Hygiene
- Regular hand washing with soap and water every time you shake hands with someone.
- No use of sanitizer as it has no effect on C. difficile.
- Environmental Cleaning and Disinfection
- Cleaning by using chlorine-containing disinfectant or other sporicidal agents.
- Visitor Management
- It includes restrictions on the number of visitors and educating them about the precautionary actions.
Antibiotic Resistance
C. difficile is found to be resistant to multiple antibiotics like lincomycin, erythromycin, tetracyclines, penicillins, cephalosporins and aminoglycosides. Recent studies published between 2012 to 2015, showed resistance patterns as 8.3-100% against Clindamycin, 51%, 47%, and 13-100% against Cephalosporins, Fluoroquinolones and Erythromycin respectively. Resistance to second-generation Cephalosporins and Fluoroquinolones is very common. However, certain strains of C. difficile show resistance towards third-generation Cephalosporins and broad-spectrum Fluoroquinolones. Metronidazole and Vancomycin are the first line drugs used for the treatment of infection by C. difficile.
Conclusion
C. difficile is the main cause of hospital-acquired infection which has the ability to produce spores to resist environmental stresses like heat and desiccation. It is responsible for the production of toxins which can lead to various clinical manifestations ranging from mild diarrhea to severe intestinal conditions.
References
- Henrich, T. J., Krakower, D., Bitton, A., & Yokoe, D. S. (2009). Clinical risk factors for severe Clostridium difficile–associated disease. Emerging Infectious Diseases, 15(3), 415–422. https://doi.org/10.3201/eid1503.080312
- Fernández-GarcÃa, L., Blasco, L., López, M., & Tomás, M. (2017). Clostridium difficile infection: Pathogenesis, diagnosis and treatment. In Clostridium difficile – A comprehensive overview (Chapter). InTech. https://doi.org/10.5772/67754
- Quality Insights Staff. (2024, November 7). How is C. diff spread? Understanding transmission and preventing contagion of C. difficile infections. Quality Insights. https://www.qualityinsights.org/quality-quest/how-is-c.-diff-spread-understanding-transmission-and-preventing-contagion-of-c.-difficile-infections
- Schwartz, O., Rohana, H., Azrad, M., Shor, A., Rainy, N., Maor, Y., Nesher, L., Sagi, O., & Peretz, A. (2024). Virulence factors, antibiotic susceptibility and sequence type distribution of hospital-associated Clostridioides difficile isolates in Israel, 2020–2022. Scientific Reports, 14(1), 20607. https://doi.org/10.1038/s41598-024-71492-2
- Tijerina-RodrÃguez, L., Villarreal-Treviño, L., MorfÃn-Otero, R., Camacho-OrtÃz, A., & Garza-González, E. (2019). Virulence factors of Clostridioides (Clostridium) difficile linked to recurrent infections. Canadian Journal of Infectious Diseases and Medical Microbiology, 2019, Article 7127850. https://doi.org/10.1155/2019/7127850
- Buddle, J. E., & Fagan, R. P. (2023). Pathogenicity and virulence of Clostridioides difficile. Virulence, 14(1), 2150452. https://doi.org/10.1080/21505594.2022.2150452
- Vaishnavi, C. (2021). Virulence factors associated with Clostridiodes difficile: An overview. Journal of Gastrointestinal Infections, 11(1), 24–29. https://doi.org/10.5005/jp-journals-10068-3047
- Mada, P. K., & Alam, M. U. (2024). Clostridioides difficile infection. In StatPearls [Internet]. StatPearls Publishing. https://www.ncbi.nlm.nih.gov/books/NBK431054/
- Lamont, J. T., Bakken, J. S., & Kelly, C. P. (2025). Clostridioides difficile infection in adults: Epidemiology, microbiology, and pathophysiology. In UpToDate. UpToDate, Inc. Retrieved [date you accessed it], from https://www.uptodate.com/contents/clostridioides-difficile-infection-in-adults-epidemiology-microbiology-and-pathophysiology
- Mayo Clinic Staff. (2023, September 1). C. difficile infection – Symptoms and causes. Mayo Clinic. https://www.mayoclinic.org/diseases-conditions/c-difficile/symptoms-causes/syc-20351691
- Chung, H.-S., et al. (2024). Laboratory diagnosis of Clostridioides difficile infection: Guidelines and status of practice in Korea. Annals of Clinical Microbiology, 27(1), 3–10.
- Mayo Clinic. (2023, September 1). C. difficile infection – Diagnosis and treatment. Mayo Clinic. https://www.mayoclinic.org/diseases-conditions/c-difficile/diagnosis-treatment/drc-20351697
- College of American Pathologists. (2023). Clostridioides (Clostridium) difficile testing (Version 2.0). https://documents.cap.org/documents/ClostridiffTesting.FullModule2.0.13APR23.pdf